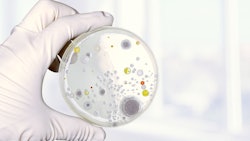

Shortly after transitioning from the cut flower industry to cannabis cultivation in 2015, the Brand family started noticing these “little creepy crawly guys” throughout their greenhouses along the Santa Barbara coastline in Carpinteria, Calif.

These orange and black insects along with the appearance of spotless ladybugs that came with them were a bit of a mystery to the Brands, who had been on their southern California farm for three decades at the time.
Family patriarch Hans Brand moved to Carpinteria from Holland in 1985, when he was 18. His daughter, Hanna Brand, and son, Johnny Brand, are now sixth-generation family farmers who remain connected to their Dutch heritage but also committed to trailblazing a path of their own.
While their ancestors grew cut flowers and vegetables in Holland greenhouses, Hanna and Johnny are now dedicated to cultivating roughly 247,000 square feet of sun-grown cannabis—along with 23,000 square feet of processing space—while utilizing no-spray, pesticide-free cultivation techniques for Autumn Brands, a 50% women-owned operator. Along with the three Brands, Autumn Shelton is a partner and the chief financial officer for the company.
Like many families in Carpinteria, the Brands spent decades filling their greenhouses with all types of flowers, notably Gerbera daisies, lilies, tulips, lisianthus, matricaria and hydrangeas. At the height of their business, they were selling roughly 100 million stems per year under B and H Flowers Inc., which was founded by Jan and Arida Brand in 1986.
But in 2015, when the cut flower industry “wasn’t going anywhere strong,” as Hanna puts it, something needed to change. Cannabis became a lifeline for the Brand family and others in the region. And while growing cannabis offered some parallels to the cut flower industry, the two are vastly different.
“We’ve really approached this like a plant that you’re trying to optimize and give everything it needs to succeed and yield quality buds and not cause stress or pressures that could result in having other issues,” Hanna says. “And so, there’s been a lot of people that have come here and tried to give some advice … but we kind of hone in more on the science of agriculture and how we were brought up and the knowledge that we have.”
Notably, the team at Autumn Brands is dedicated to creating a natural ecosystem, and that means utilizing a no-spray, 100% biocontrol program for its pesticide-free cultivation practices. The Brands also incorporate hydroponic methods as well as earth elements like sustainably sourced coco coir fertilizer in the grow process that keeps their carbon footprint small.
Unlike the vegetables Hanna and Johnny’s ancestors grew in Holland, cannabis can’t be taken home and washed. Motivated by this reality, the Autumn Brands team lives by the saying, “You can’t wash your weed.”
In Gerbera daisies, a plant that consistently produces flowers over a roughly two-year lifecycle, the Brands were conscious about workplace safety and how much they sprayed their plants. They kept in mind that their end cut flower products went into people’s homes but were not intended for consumption, Hanna says.
Editor’s note: For guidance on the use of pesticides in the cultivation of cannabis in California, visit the state’s Department of Pesticide Regulation (DPR) website. The California DPR has a list of acceptable pesticides as do other states with regulated cannabis markets.
But with the transition to cannabis, Autumn Brands decided to go 100% spray free and pesticide free for the first time in the family’s agricultural practices.
“For cannabis, we are putting it in the flowering greenhouse for about seven to nine weeks, and you’re harvesting the whole plant and starting new with the veg plants that you have,” Hanna says. “And so, the life cycle is faster, which makes the need for pesticides reduced, because you can really combat it with [other] tools, searching for genetics that are more resistant to issues like powdery mildew, and then also controlling, since we are in a greenhouse—we still have a lot of control over our climate.”

Many of the OG cultivars Autumn Brands grew early on were not as resistant to powdery mildew, Hanna says the team in Carpinteria noticed. Also, the team found that Blue Dream crossed with a cultivar that has citrus notes was prone to attracting more aphids. So, while Autumn Brands still grows a Blue Dream CBD, the company decided to take its Blue Dream sativa genetics out of its system.
With regard to environmental controls, Autumn Brands utilizes a computerized windows system that changes with the direction of the wind to help mitigate certain plant diseases: In cannabis cultivation, proper air flow and circulation is crucial to help ensure plant growth is not stunted and mildew or bug programs don’t occur via microclimates. But that alone wasn’t a turnkey solution, and the team still lost a lot of plants during its early harvest days seven, eight years ago.
When they first transitioned from cut flowers to cannabis in 2015, the Brands ended up dedicating a full harvest to oil production because the quality of their flower wasn’t where they wanted it to be, says Hanna, who also uses Autumn Brands’ products and, in turn, holds them to high standards.
“When we really shrunk our toolbox down to beneficial insects, climate control and genetics control of what we were purchasing and testing, that’s where we kind of found our magic solution,” she says. “But there still are times where we bring in strains, and we think … that they’re going to work, and they don’t work. And so, we’ve just kind of learned to bring in small batches and then grow from there.”
Having earned a degree in Environmental Horticulture Science at California Polytechnic State University (Cal Poly), Hanna’s leadership provides Autumn Brands with a continuous focus on quality control and higher yields, among other key businesses benchmarks.
And the No. 1 key for Autumn Brands to provide consistent products that stay true to the company’s core values is its biocontrol, she says.
In Carpinteria, the Autumn Brands workers buy beneficial mites that eat bad mites, and they have wasps that lay their eggs into aphids, and then the next generation of wasps will eat the aphids from the inside out until they’re entirely wiped out.
But the team experienced a “hiccup” one year when they decided to defoliate the bottoms of their plants, a tactic many indoor cultivators use to promote greater airflow and light penetration in order to try and foster larger bud sites and higher THC content.
“We wanted to try it, and we noticed that when we did that, we lost a lot of our beneficials because they’re regenerating on their own in our greenhouses,” Hanna says. “When we removed those bottom leaves, we were destroying a lot of the habitat for the regeneration. And so, we were having to buy a lot more.”
Protecting beneficial insects is also a reason why Autumn Brands does not spray its plants, Hanna says. “What happens is if you put out your beneficials on Thursday and then you spray on Sunday, you didn't just kill your pests, you killed a ton of your beneficials you just paid for,” she says.
Beyond dialing in these specifics, once the Brands transitioned to cannabis cultivation and stopped spraying their plants, these “creep crawly guys” started showing up—the region’s native ladybug larvae.
“We also found ladybug eggs,” Hanna says. “They’re laying their eggs underneath the underside of our leaves of our plants and hatching, and then adults are flying around with no spots. And … UC Santa Barbara reached out after seeing a video of us being like, ‘We don’t know why they don’t have spots.’ And that’s when we found out that those are native, and they don’t cluster like the ones you can purchase or the European ladybugs.”

Michelle Lauren | Autumn Brands
“Ladybugs are never going to lay their eggs where anyone has used pesticides,” Hanna says. “And when you [bring] ladybugs in as a beneficial, they normally fly away and go to your neighbor's home garden that doesn’t use pesticides. So it’s really a way for us to show these ladybugs are here in our greenhouses because we are no spray.”
Also earning a degree from Cal Poly—in Agricultural Business—Johnny determined how to establish a natural balance on the farm that allows aphids to survive, just enough not to affect the cannabis output too drastically, leading to the native California ladybugs to come to Autumn Brands to lay their eggs voluntarily. Their eggs turn into larvae and eat the aphids in their path.
To represent Autumn Brands’ integrative growing techniques, the company has adopted a ladybug “PURE” mark on its branded products—an acronym for pesticide-free, user-first, responsibly grown and eco-friendly cannabis products.
“[The PURE mark is] really our staff to say that we aren’t just telling you that we’re spray-free and then closing our curtains on Sunday and spraying; we mean it. Come into our greenhouses, see our ladybugs,” Hanna says.
In addition to its no-spray, pesticide-free cultivation practices, Autumn Brands is keen on sustainability. In particular, the team utilizes a closed-loop watering system from a natural well on the farm, ensuring no water is wasted using hydroponic methods.
Notably, the Brands have operated on their current property for more than 35 years now, and, as good stewards of the land, they pull straight from their well water for all of their irrigation, mix their own sustainably sourced coco coir fertilizer on-site, and then they collect all the drainage from their plants. It then goes through filtration and is used in the next watering cycle so that the only water they’re losing is actually transpiring out of the leaves of the plants being grown.
“It's really amazing because we have no nitrates in our well,” Hanna says. “My family has taken care of this property and not leached back into the soil or leached [nitrates] into the well water, which is a big concern with the California Water Board.”
In addition, all organic waste is composted at Autumn Brands, and the company’s packaging is consciously chosen to be reused or composted. While Autumn Brands doesn’t want to create a ton of waste with its packaging, it also wants to make sure its products are lifetime child resistant, Hanna says.
That said, all of Autumn Brands’ glass jars have child-resistant, home-compostable lids from Humidi.

“They aren’t the 15-year biodegradable option,” Hanna says. “They're backyard, home compostable. So all you have to do is take off the sticker on the top, and you can bury it in the dirt or throw it in compost. And I thought that was a really cool option.”
Autumn Brands also reduced its glass usage by 25% when it switched from 40-dram to 30-dram jars from eBottles for its 3.5-gram flower products. And the company switched from plastic to recyclable tin for its preroll packaging. The Autumn Brands team also uses short-life, 1-gram tubes from A&A Global that take two years instead of 15 years to biodegrade.
And although Autumn Brands’ commitment to sustainability, consistency, consumer safety and pesticide-free cultivation doesn’t always add dollars to its profit line, Hanna says she and her team take pride in knowing they’re doing things their way and sticking to their values.
“When we set up this company and pounds were worth three times the price of what they are now, we knew it was going to come down and [cannabis] wasn’t going to be this very expensive product forever,” she says. “And so, we kind of grew in our means of we didn’t massively overexpand.”
And although running a profitable cannabis cultivation business has become more difficult amid price compression and myriad regulatory hurdles in the past two years, Hanna says, “I don’t think any of us regret being here.”
The Brands also find pride and satisfaction in knowing they’re sticking to their ancestral roots. Hanna says she and her brother Johnny are surrounded by their paternal and maternal cousins in Carpinteria’s coastal valley, and they know almost everyone working or running the other greenhouses around them.
“But I think my brother and I have a real sense of pride that we’re doing it our way, and we’re not going the commercial way of the most product, and we have to dry fast, and we have to get it out of here because we have to get cash flow,” Hanna says. “We’re giving the plant the time that it needs. We want people to come to us and say, not only, ‘Oh, you have great weed,’ but, ‘Your cannabis smells amazing. The moisture is correct, the color, the look is correct,’ and that they can rely on it.”
If the Brands are going to do something, she says, they might as well do it to the best of their ability.